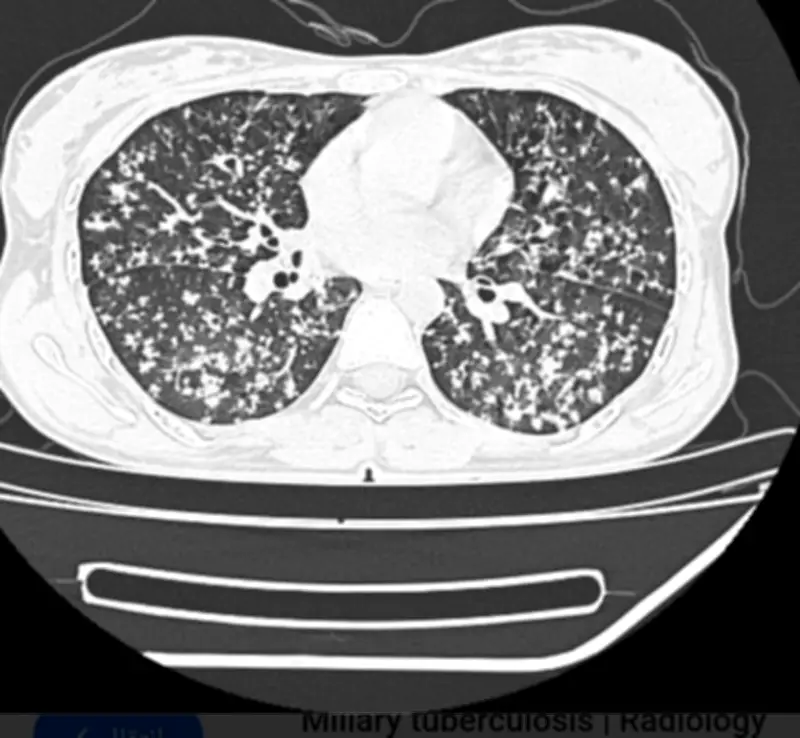

فريق طبي بمستشفى المانع بالأحساء ينقذ مريضاً من حالة حرجة
في إنجاز طبي بارز، تمكن فريق طبي متخصص في مستشفى المانع العام بمدينة الأحساء من إنقاذ حياة مريض كان يعاني من حالة صحية خطيرة، حيث تم تشخيص إصابته بمرض السل الرئوي المنتشر، مصحوباً بنقص حاد في مستويات الأكسجين في الدم.
تفاصيل الحالة والتدخل الطبي
وصل المريض إلى المستشفى وهو في وضع صحي حرج، مع أعراض تشير إلى ضيق شديد في التنفس وارتفاع في درجة الحرارة. وبفضل الكفاءة العالية للفريق الطبي، تم إجراء الفحوصات اللازمة على الفور، والتي كشفت عن انتشار العدوى الرئوية ونقص الأكسجين الحاد.
قام الأطباء بتطبيق خطة علاجية مكثفة وشاملة، تضمنت:
- توفير الأكسجين الطبي لتعويض النقص الحاد.
- إعطاء الأدوية المضادة للسل وفق بروتوكولات علاجية محددة.
- مراقبة مستمرة للحالة الصحية للمريض لضمان استقراره.
نتائج إيجابية وتطور الحالة
بعد أيام من الرعاية المركزة، بدأت حالة المريض تتحسن بشكل ملحوظ، حيث استعاد مستويات الأكسجين الطبيعية وتراجعت أعراض المرض. وأكد الفريق الطبي أن المريض يستجيب بشكل إيجابي للعلاج، مما يعد مؤشراً على نجاح التدخل الطبي السريع والدقيق.
يُذكر أن هذا الإنجاز يعكس التطور الكبير في الخدمات الصحية بالمملكة، وخاصة في المناطق مثل الأحساء، حيث تسهم المستشفيات في تقديم رعاية طبية متقدمة تنقذ الأرواح.









